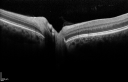

Last additions - Neuro-Ophthalmology Photos David Smith Neuroophthalmology Photos
|

530 viewsJun 03, 2011
|
|

414 viewsJun 03, 2011
|
|

374 viewsJun 03, 2011
|
|

375 viewsJun 03, 2011
|
|
359 viewsJun 03, 2011
|
|

448 viewsJun 03, 2011
|
|

413 viewsJun 03, 2011
|
|

468 viewsJun 03, 2011
|
|

520 viewsJun 03, 2011
|
|

424 viewsJun 03, 2011
|
|

410 viewsJun 03, 2011
|
|

331 viewsJun 03, 2011
|
|

397 viewsJun 03, 2011
|
|

360 viewsJun 03, 2011
|
|

364 viewsJun 03, 2011
|
|

336 viewsJun 03, 2011
|
|

369 viewsJun 03, 2011
|
|

383 viewsJun 03, 2011
|
|

408 viewsJun 03, 2011
|
|

406 viewsJun 03, 2011
|
|

438 viewsJun 03, 2011
|
|

417 viewsJun 03, 2011
|
|

417 viewsJun 03, 2011
|
|

452 viewsJun 03, 2011
|
|

572 viewsJun 03, 2011
|
|
|
|
|
|
David Smith Neuroophthalmology Photos